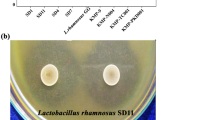

Abstract
Bacteriocin-producing Escherichia coli ICVB442, E. coli ICVB443, Enterococcus faecalis ICVB497, E. faecalis ICVB501, and Pediococcus pentosaceus ICVB491 strains were examined for their pathogenic risks and compatibility and hence suitability as consortium probiotic bacteria. Except for E. coli ICVB442, all were inclined to form biofilm. All were gelatinase-negative, sensitive to most of the antibiotics tested and not cytotoxic to porcine intestinal epithelial cells (IPEC-1) when tested at a multiplicity of infection (MOI) of 1. P. pentosaceus ICVB491 stood apart by inhibiting the other four strains. Both E. coli strains and E. faecalis ICVB497 strain were β-hemolytic. Survival in the TIM-1 dynamic model of the human digestive system was 139% for the tested E. coli ICVB443 strain, 46% for P. pentosaceus ICVB491, and 32% for the preferred E. faecalis ICVB501 strain. These three potential probiotics, which are bacteriocin-producing strains, will be considered for simultaneous use as consortium with synergistic interactions in vivo on animal model.
Similar content being viewed by others
Avoid common mistakes on your manuscript.
Introduction
Antibiotics have been used widely and massively as growth promoters and therapeutic agents to stop infectious diseases in livestock [1]. Indeed, so-called growth promotion is a sparing effect on the animal immune system, which would otherwise be a metabolic burden on livestock performance. This practice has been profitable for farmers, allowing production with huge economies of scale and minimal animal death due to pathogenic bacteria. The price paid for this boon has been the development of a reservoir of bacterial resistance to antibiotics, now called the “resistome,” which includes multi-resistant strains that are transmissible throughout the production chain [2]. Even more troubling, residues of antibiotics can end up in human foods, especially meat and its derivatives. Consequently, the use of antibiotics as growth promoters has been prohibited in the European Union (under directive 2001/82/CE) and in other countries [3]. Total replacement of antibiotics in livestock production has bolstered the development of new strategies of pathogen control, including the use of probiotics [4]. According to the United Nations Food and Agriculture Organization, probiotics are “live microorganisms, which when administered in adequate amounts, confer a health benefit to the host” [5]. The key criteria for selecting a microbial strain as a probiotic are safety, survival under gastrointestinal conditions, and ability to inhibit pathogens [6]. Most probiotics approved so far are species of lactic acid bacteria [3, 7, 8]. However, other bacteria have been evaluated, such as Escherichia coli Nissle 1917, a potent inhibitor of Salmonella spp. as well as other enteric pathogens and now used in the first approved probiotic formulation [9]. Studies of potential pathogenic properties are required in order to qualify strains of E. coli or Enterococcus spp. as probiotic candidates. These non-GRAS species then have to be evaluated for bacteriocin production and survival in the gastrointestinal tract, in particular in the presence of bile salts and at low pH [10,11,12]. Their responses to unabsorbed dietary starch, non-caloric polysaccharides such as fiber and oligosaccharides (major sources of carbon and energy for some probiotics) and mucin (an inexhaustible source of oligosaccharides and glycoproteins in the gastrointestinal tract) also have to be evaluated [13, 14]. Strains of non-GRAS genera such Entercoccus sometimes meet these requirements [15]. Notwithstanding non-GRAS status and even potential antibiotic resistance, Enterococcus-based probiotic formulations have been developed and marketed. Examples are Symbioflor 1 (SymbioPharm, Herborn, Germany) and E. faecium SF68® or NCIMB 10415 (Cerbios-Pharma SA, Barbengo, Switzerland) [16], which are currently used for preventing or treating diarrhea in pigs [17]. Probiotic strains of E. coli produce bacteriocins called colicins [18], which were in fact the first bacteriocins to be characterized [19]. Of note, the antimicrobial spectrum of colicins includes pathogenic vancomycin-resistant enterococci [20], and pathogenic strains of E. coli [21, 22]. They bind to specific receptors on targeted cells and form voltage-dependent channels into the inner membrane [23].
Pediococcus has received GRAS status, and strains of P. pentosaceus and P. acidilactici offer ideal probiotic profiles and are already being used as probiotic supplements in animal feed [8]. As for enterococci, one of notable advantages of pediococci is the production of bacteriocins that tolerate gastrointestinal conditions [24]. These bacteriocins are pH-stable and temperature-stable [25,26,27,28]. They bear the N-terminal YGNGV(L) sequence that typifies class IIa bacteriocins and they act through membrane permeabilization or by binding to specific receptors [29, 30].
Probiotic formulations usually contain a single well-characterized strain. However, recent studies show benefits of probiotics based on multiple strains [31, 32]. To develop new therapeutic options for infections by Gram-negative or Gram-positive bacilli in farming and veterinary medicine, we recently isolated strains of E. coli, E. faecalis, and P. pentosaceus from livestock (swine) and claimed their bacteriocin-producing features [33].
In this study, we gained more insights and characterize these strains for their potential health risk, mutual compatibility, and survival under gastrointestinal conditions (TIM-1 dynamic model), allowing to evaluate their suitability as probiotic strain as standalone or mixed in a consortium.
Material and Methods
Bacterial Strains and Growth Conditions
Escherichia coli ICVB442 and ICVB443, E. faecalis ICVB497 and ICVB501, and P. pentosaceus ICVB491 strains were isolated and characterized for their probiotic characters, mainly their antimicrobial activity against Gram-positive and Gram-negative pathogens in a previous report focused on drops of animals living in captivity at the zoological garden of Lille (France) [33]. E. coli ICVB442 and ICVB443 as well as E. faecalis ICVB497 and ICVB501 strains were grown in brain heart infusion (BHI) medium (Sigma Aldrich, St Louis, MO, USA) at 37 °C for 24 h. P. pentosaceus ICVB491 strain was grown at 37 °C for 24 h in de Man, Rogosa, and Sharpe (MRS) [34] broth (Sigma Aldrich). In addition, the probiotic Lactobacillus rhamnosus GG (ATCC 53103) was used as control strain to assess biofilm formation, whereas E. faecalis Symbioflor®1 probiotic strain, Clostridium perfringens DSM 756 pathogenic strain, E. faecalis ATCC 700802, and E. coli ATCC 25922 reference strains were also used as controls for cytotoxicity assays. Staphylococcus aureus ATCC43300 and C. perfringens DSM 756 were used as control strains for hemolysis, antibiotics resistance, and assessment of gelatinase activity.
Evaluation of Pathogenic Properties of the Bacteriocin-Producing Strains
Resistance to Antibiotics
Overnight broth culture of each strain was diluted in peptone water (5 μL in 5 mL). The P. pentosaceus ICVB491 suspension was spread on MRS agar, whereas E. coli ICVB442, ICVB443, and E. faecalis ICVB497, ICVB501 strain suspensions were spread on Mueller-Hinton agar (Sigma Aldrich). Antibiotic discs (Becton-Dickenson, Mississauga, Canada) were deposited on the agar surface, and the plates were incubated overnight at 37 °C. E. coli was tested with gentamycin (10 μg), ampicillin (10 μg), ciprofloxacin (5 μg), cefoxitin (30 μg), nalidixic acid (30 μg), ceftazidime (30 μg), or cefotaxime (30 μg). P. pentosaceus was tested with penicillin (10 μg), gentamycin (10 μg), erythromycin (15 μg), cefotaxime (30 μg), ciprofloxacin (5 μg), trimethoprim-sulfamethoxazole (1.25/23.75 μg), and vancomycin (30 μg). E. faecalis was tested with ciprofloxacin (5 μg), ampicillin (10 μg), gentamycin (10 μg), vancomycin (30 μg), streptomycin (10 μg), chloramphenicol (30 μg), erythromycin (15 μg), and trimethoprim-sulfamethoxazole (1.25/23.75 μg). Antibiotic susceptibility was interpreted in accordance with Clinical and Laboratory Standards Institute (CLSI) recommendations [35], based on the diameter of the zone of inhibition formed around each disc.
Hemolytic Activity
Hemolytic activity was evaluated on Mueller-Hinton agar into which defibrinated sheep blood (5% v/v, Nutri-Bact, Terrebonne QC, Canada) was blended just before solidification (at 41 °C). Then, 18 h cultures at 37 °C in BHI broth (for E. coli ICVB442, ICVB443 and E. faecalis ICVB497, ICVB501 strains) or in MRS broth (for P. Pentosaceus ICVB 491) were used. The broth cultures were streaked onto the blood agar plates and incubated for 36 h at 37 °C. Based on the zone of clearing, hemolytic activity was described as β-hemolysis (complete) or α-hemolysis (partial).
Gelatinase Production
Gelatinase activity was determined using Petri plates containing nutrient medium agar supplemented with 5% (w/v) gelatin (BDH Chemicals, Ltd., Poole, UK). The agar surface was inoculated by streaking the tested strain grown in its usual culture broth. After incubation for 2 to 5 days at 37 °C, Frazier reagent (HgCl2 12 g, HCl 20 mL, distilled water 20 mL) was added to reveal the hydrolysis. Formation of a halo around a colony indicated gelatinase activity.
Biofilm Formation Ability
Biofilm formation was quantified according to a method published previously [36]. E. coli ICVB442, ICVB443 and E. faecalis ICVB497, ICVB501 strains were grown overnight in 3 mL of BHI broth, whereas P. pentosaceus ICVB491 and Lb. rhamnosus GG (ATCC 53103) were grown in MRS broth. Polystyrene micro-assay plates were loaded with broth (230 μL per well) and 20 μL of overnight culture were added in triplicate. Wells containing medium only were negative controls, whereas those containing Lb. rhamnosus GG (ATCC 53103) were positive controls. After incubation for 24 h at 37 °C, the culture (or broth) was poured off, and the wells were washed three times with 300 μL of sterile ultrapure water. Methanol (250 μL) was added to fix adherent bacteria for 15 min. The wells were then emptied, air-dried, stained for 5 min with 250 μL of crystal violet, and the assay plate was placed under running tap water to remove excess stain. After air-drying, 250 μL of 33% (v/v) glacial acetic acid (Sigma Aldrich) were added to each well to resolubilize the dye bound to adherent cells. The OD570 nm was determined for each well using a PowerWave XS2 automated 96-well assay plate reader (Bio-Tek Instruments, Winooski, VT, USA). The cutoff OD (ODc) was defined as the mean OD570 nm of the negative control values plus three standard deviations. Strains were classified on the following basis: OD570 nm ≤ ODc = non-adherent, ODc < OD570 nm ≤ 2 × ODc = weakly adherent and 2 × ODc < OD570 nm = strongly adherent. The ODc was determined for BHI and MRS broths.
Cytotoxicity Assay on the Porcine Intestinal Epithelial Cell Line IPEC-1
The cytotoxicity of bacteriocin-producing strains was determined using a porcine intestinal epithelial cell line-1 called IPEC-1 (DSMZ, Braunschweig, Germany) grown to confluence in the wells of micro-assay plates. The assay is based on measurement of lactic dehydrogenase activity released into the culture medium by lysed cells. Each strain was tested at a concentration 105 cfu/mL or 107 cfu/mL for multiplicity of infection (MOI) equal to 1 or 100. Cultures were centrifuged (8228g, 10 min, 4 °C), washed twice with 4 mL of phosphate-buffered saline (NaCl 137 mmol/L, KCl 2.7 mmol/L, Na2HPO4 10 mmol/L, KH2PO4 1.8 mmol/L), and resuspended in Dulbecco’s modified Eagle’s medium (DMEM, Gibco, Thermo Fisher Scientific, Inc., Waltham, MA, USA) with 10% fetal bovine serum and no antibiotics. The IPEC-1 cells were washed twice to remove the culture medium completely then covered with 100 μL of bacterial suspension. DMEM was used as a negative control. The plates were then incubated for 24 h at 37 °C and 5% (v/v) CO2. Probiotic Symbioflor®1, C. perfringens DSM 756, Enterococcus faecalis ATCC 700802, and Escherichia coli ATCC 25922 were also used as controls. After incubation, 50 μL from each well were transferred to another micro-assay plate for testing with the lactate dehydrogenase substrate, dye, and cofactor (Sigma Aldrich) added as solutions at a 1:1:1 (v/v/v) ratio (100 μL total). The plate was returned to the incubator for 20–30 min. The absorbance in each well was then measured at 490 nm and subtracted from the absorbance at 690 nm. Epithelial cell viability was calculated from the absorbance relative to the negative control.
Mutual Compatibility of the Bacteriocin-Producing Strains
A cross-inhibition assay was performed using the deep-well diffusion method [37]. Overnight culture at 37 °C in 3 mL of BHI (E. coli ICVB442; ICVB443 and E. faecalis ICVB497; ICVB501) or MRS (P. pentosaceus ICVB491) was centrifuged (8334g, 8 min, 4 °C). Half of the supernatant was adjusted to pH 7.0. Both portions were tested in wells in BHI or MRS agar seeded with one of the five strains [38]. Plates were incubated overnight at 37 °C. The presence of an inhibition zone indicated inhibitory activity.
The compatibility assay was performed by re-suspending the centrifugal pellet in 200 μL of supernatant of another strain in micro-assay wells. BHI or MRS broth was used as a positive control and uninoculated broth was used as a negative control. The OD600 was measured every 15 min during 36 h of incubation at 37 °C. The plate was agitated gently before each measurement. The Tlag (time elapsed upon the initial 0.01 increase in optical density) and μmax (specific growth rate at the inflection point) were calculated from the OD600 graph. Peak optical density (ODmax) was noted.
Survival Under Gastrointestinal Conditions
The tenacity of each strain in situ was evaluated using the TIM-1 dynamic model of the human digestive system (TNO Nutrition and Food Research Institute, Zeist, Netherlands), which consists of four flexible compartments connected in series mimicking the stomach, duodenum, jejunum, and ileum. Computer-controlled pumps produce peristaltic movement using external water pressure. Two independent sensors connected to the stomach and small intestine compartments allow temperature control (set at 37 °C). A sensor mounted in each compartment allows monitoring and control of pH. The gastric pH was started at 6.5 and decreased gradually to 3.5 at 30 min, 1.8 at 60 min, and 1.7 from 120 min to the end of digestion at 300 min. The duodenal pH was kept at 6.0, the jejunal pH at 6.5, and the ileal pH at 7.2. Hollow-fiber modules connected to the jejunal and ileal compartments allow dialysis against small intestinal electrolyte solution to simulate absorption. Gastric secretions were composed of 150 U/mg lipase and 3200 U/mg pepsin in gastric electrolyte solution (NaCl 6.2 g/L, KCl 2.2 g/L, CaCl2 0.3 g/L, NaHCO3 1.5 g/L). Porcine bile extract and 8xUSP pancreatin dissolved in small intestine electrolyte solution (NaCl 5.0 g/L, KCl 0.60 g/L, CaCl2 0.30 g/L) were injected into the duodenal compartment. The jejunal and ileal compartments were filled initially with small intestine electrolyte. A test protocol described previously [39] was used with minor modifications. Briefly, 310 mL of skim milk inoculated with 3 mL of culture were added to the gastric compartment. Aliquots of 500 μL were removed therefrom at 0, 30, 60, 90, and 120 min, after 30, 60, 90, 120, and 150 min from the duodenal compartment, and after 60, 120, 180, and 240 min from jejunal and ileal compartments. The effluent was collected, weighed, and aliquoted at 60, 120, 180, 240, and 300 min. The semifluid mass that passed from the stomach to the duodenum intestine at 300 min (chyme) was also weighed.
Viable counts were determined from serial dilutions (to 10−6) in sterile 1% (v/v) peptone water (Thermo Fisher Scientific Inc.). E. faecalis ICVB501 was counted on bile esculin agar (selective for group D streptococci), E. coli ICVB443 on eosin methylene blue agar (selective for coliforms), and P. pentosaceus ICVB491 on MRS agar. Plates were spread in duplicate and incubated at 37 °C for 24 h. Counts were expressed as decimal logarithm (log10) colony forming units (cfu) per mL of skim milk.
Statistical Analyses
The IPEC-1 viability test was performed in triplicate. The mutual compatibility experiment was performed twice, independently for each strain. Data were analyzed using SAS software (SAS Institution, Cary, NC, USA) and expressed as mean ± standard deviation. One-way analysis of variance (ANOVA) with the Tukey multiple comparisons test was used to identify significant differences between treatments (P < 0.05).
Results
Antibiotic Susceptibility Was Strain-Dependent
Based on CLSI interpretation [35], E. coli ICVB442, ICVB443, and E. faecalis ICVB497, ICVB501 were sensitive to all of the antibiotics tested. However, E. faecalis showed intermediate resistance to trimethoprim-sulfamethoxazole. P. pentosaceus ICVB491 was also sensitive, except to ciprofloxacin, trimethoprim-sulfamethoxazole, and vancomycin, to which pediococci are generally resistant [40, 41].
Hemolysis and Gelatinase
E. coli ICVB442, ICVB443, and E. faecalis ICVB497 colonies produced clear zones on blood agar, indicating β-hemolysis. Neither E. faecalis ICVB501 nor P. pentosaceus ICVB491 displayed this undesirable trait (results not shown). All five strains were gelatinase-negative.
Biofilm Formation
The control optical density was 0.145 in BHI broth and 0.149 in MRS broth. E. coli ICVB442 was non-adherent (OD less than half the ODc), in other words, little or no tendency to form biofilm [42]. E. coli ICVB443 (OD = 0.511), E. faecalis ICVB497 (0.680), and P. pentosaceus ICVB491 (0.794) were strongly adherent (OD more than twice the ODc). E. faecalis ICVB497 (0.373) was weakly adherent [42]. The OD obtained for Lb. rhamnosus GG (used as a strong positive control) was 0.658.
Cytotoxicity at Low Concentrations
Cytotoxicity is deemed significant when the IPEC-1 cell layer viability is around 50%, moderate at 60–80%, low at 80–99%, and negative at 100% [43]. As shown in Fig. 1 A and B, C. perfringens was highly cytotoxic at both MOI. Symbioflor® 1, E. faecalis (ICVB497, ICVB501), and P. pentosaceus ICVB491 strains displayed low cytotoxicity at both MOI as no significant difference (P > 0.05) was noticed compared with the untreated IPEC-1 cells, used as controls (Fig. 1A, B). The cytotoxicity of E. faecalis ATCC 700802 was low at a MOI of 1 and moderate at 100. E. coli ATCC 25922 and E. coli ICVB442 showed low cytotoxicity at 1 and high at 100 with percentage of IPEC-1 cells viability significantly (less than 50%) lower (P < 0.05) than the control (Fig. 1B). E. coli ICVB443 was non-toxic at 1 but highly toxic at 100.
Viability of IPEC-1 cells, expressed in percentage, in the presence of E. coli ICVB442, E. coli ICVB443, E. faecalis ICVB497, E. faecalis ICVB501, P. pentosaceus ICVB491, E. faecalis Symbioflor® 1, E. coli ATCC 25922, E. faecalis ATCC 700802, and C. perfringens DSM 756 with a 1:1 MOI (multiplicity of infection) bacterial cell/IPEC-1 cell of 1 (□); and MOI of 100 (■). Values are mean ± standard deviation; different letters indicate significant difference (P < 0.05)
Compatibility of the Probiotic Candidate Strains
P. pentosaceus ICVB491 culture supernatant inhibited the growth of the four other bacteriocin-producing strains (Fig. 2A). No E. facealis or E. coli strain reached an ODmax of even 0.2 in its presence. Both E. faecalis strain culture supernatants had a limited effect on the other strains as no significant difference was noticed compared with the untreated control in most cases. Figure 2B shows that each strain, and particularly P. pentosaceus, produced something that slowed the growth rate (μmax) of the other strains significantly (P < 0.05). The P. pentosaceus ICVB491 supernatant also increased the lag time (Tlag) of all strains significantly reaching two- to tenfolds the control (Fig. 2C). Supernatant from E. faecalis ICVB497 and ICVB501 culture increased the Tlag of other strains except E. coli ICVB442, whereas E. coli ICVB443 supernatant had only a slight effect on the growth of the other strains.
Effect of culture supernatant of each bacteriocin-producing strain on the growth of the others: on E. coli ICVB442 (1) and ICVB443 (2); E. faecalis ICVB497 (3) and ICVB501(4); and P. pentosaceus ICVB491 (5). Left to right for each strain: control, CFS of E. coli ICVB442, of E. coli ICVB443, of E. faecalis ICVB497, of E. faecalis ICVB501, and of P. pentosaceus ICVB491. A On ODmax. B On μmax. C On Tlag. Values are mean ± standard deviation; different letters indicate significant difference (P < 0.05)
Tolerance of Gastrointestinal Conditions
Based on hemolysis, biofilm formation, and cytotoxicity, two strains (E. coli ICVB442 and E. faecalis ICVB49) were excluded from the gastrointestinal simulation experiment. E. coli ICVB443, E. faecalis ICVB501, and P. pentosaceus ICVB491 were retained for survival test in the TIM-1 model. Figure 3a shows the distribution of the skim milk among the compartments during the 5-h digestive cycle. The viable counts are shown in Fig. 3b, c, d. The initial counts of E. coli ICVB443, E. faecalis ICVB501, and P. pentosaceus ICVB491 in the gastric compartment were, respectively, 9.13 ± 0.01, 9.19 ± 0.08, and 9.20 ± 0.10 log10 cfu/mL. However, after remaining stable for 1 h, the E. coli count fell to 7.79 log10 cfu/mL while E. faecalis dropped to the 5.51 log10 cfu/mL range and P. pentosaceus to the 4 log10 cfu/mL range. In the duodenal compartment, E. coli and P. pentosaceus viable counts decreased by 1 log after 2 h. Viable E. faecalis increased by nearly 1 log during the first hour, then dropped to 8 log10 cfu/mL and remained at that level. The viable counts of the 3 strains remained relatively stable during the passage through the jejunum and the ileum until the end of the simulated digestion. Survival of the proposed probiotic bacteria in the TIM-1 was 139% for E. coli ICVB443, 32% for E. faecalis ICVB501, and 46% for P. pentosaceus ICVB491.
Discussion
The use of probiotics to replace antibiotics is now widespread [4, 44, 45]. Prior to filing any claim about the probiotic value of a bacterial strain, its potential pathogenic risk and its tenacity under conditions as close as possible to those normally prevailing in the gastrointestinal tract must be evaluated [3, 8]. Strains that meet all safety, efficacy, and viability criteria can now be used in consortium formulations, which are being proposed as the next generation of probiotics [7].
In the present study, five bacterial strains were evaluated as probiotic candidates: E. coli ICVB442 and ICVB443, E. faecalis ICVB497 and ICVB501, and P. pentosaceus ICVB491. While the latter species is not a surprising choice, the two other might still raise a few brows. All were tested for antibiotic susceptibility, hemolytic and gelatinase activities, mutual compatibility, and cytotoxicity to a porcine intestinal epithelial cell line. None of these five strains exhibited a gelatinase activity, a property considered as a detrimental virulence factor for pathogenic E. coli and E. faecalis strains. This protease hydrolyse gelatin, casein, and hemoglobin, as well as other active compounds, can compromise the integrity of soft tissues [46, 47].
E. coli ICVB442 and E. coli ICVB443 strains were not resistant to the antibiotics tested. However, they were hemolytic and had a cytotoxic effect on IPEC-1 cells, albeit only at high multiplicity of infection (Fig. 1). E. coli ICVB443 was more inclined to form biofilm. Both E. faecalis ICVB497 and ICVB501 strain formed biofilm, ICVB497 somewhat more. Of note, these promising in vitro results need to be confirmed in vivo as a biofilm formation capability can help a probiotic strain to defy harsh conditions in the gastrointestinal tract, and possibly block colonization of the intestinal mucosa by pathogens [48].
Remarkably, the probiotic grade is attributed for some Enterococcus strains based taking into consideration their global safety profile and the absence of virulence factors. Neither E. faecalis ICVB497 nor ICVB501 strain displayed any antibiotic resistance, and noticeably both of them were devoid of gelatinase activity. However, E. faecalis ICVB497 has a β-hemolytic activity, which practically rules out its possible use as a probiotic. Notwithstanding some controversial aspects attributed to Enterococcus, some strains have benefitted of probiotic grade [49]. In fact, they have been tested for human use [50, 51], for example, to limit diarrheas and inflammatory bowel diseases as well as in livestock [2, 52].
Compatibility assays showed that both E. coli ICVB442, ICVB443 strains and both E. faecalis ICVB497, ICVB501 strains could function in the same probiotic formulation (Fig. 2). However, P. pentosaceus ICVB491 inhibited the other strains, likely because of the acidity of its culture supernatant (based on agar diffusion tests, results not shown), but possibly also by producing an inhibitory substance such as a bacteriocin [33].
Survival during gastrointestinal transit, a key factor for selecting new probiotic strains [53, 54], has been tested successfully in static models [53] and dynamic models [54]. The dynamic model designed 25 years ago by Minekus et al. [54] has proven its effectiveness for evaluating survival of beneficial microorganisms [55, 56] and the persistence of bacteriocins [39, 57], drugs [58,59,60], and other substances [61,62,63] in human and animal digestive tracts.
Of the three strains deemed worthy of testing in the TIM-1 in this study, E. coli ICVB443, which was retained as its non-toxic at 1 MOI, was the most robust, its final viability value reaching 139% of the initial load into the system (Fig. 3), which is consistent with previous similar studies [64]. The P. pentosaceus ICVB491 strain has interestingly revealed comparable features with P. acidilactici UL5 tested by Kheadr et al. [39], using a skim milk culture in a TIM-1 model. Pediococcus strains usually survive better than other lactic acid bacteria in the TIM-1 model [65].
Finally, at 32%, the survival of E. faecalis ICVB501 was the lowest measured in the present study, which has been observed elsewhere for enterococci under such conditions [66, 67].
Conclusion
In summary, E. coli (ICVB442 and ICVB443), E. faecalis (ICVB497 and ICVB501), and P. pentosaceus ICVB491 were tested for their suitability as parts of a consortium-type probiotic formulation. Pathogenicity and cytotoxicity tests including their antibiotic resistance, hemolysis, biofilm forming ability, and their compatibility assays enabled us to select three strains that presented suitable attributes for probiotic use. These strains are P. pentosaceus ICVB491, which belongs to species possessing GRAS status, E. coli ICVB443, and E. faecalis ICVB501 that exhibited worthy features that deserve to be tested under a dynamic model. These strains will be the focus of future research regarding the use of these colicin-producing, enterocin-producing, and pediocin-producing commensal strains, for simultaneous use as a novel consortium probiotic supplement to promote the health of piglets.
References
Wierup M (2000) The control of microbial diseases in animals: alternatives to the use of antibiotics. Int J Antimicrob Agents 14:315–319. https://doi.org/10.1016/s0924-8579(00)00143-6
Liao SF, Nyachoti M (2017) Using probiotics to improve swine gut health and nutrient utilization. Anim Nutr 3:331–343. https://doi.org/10.1016/j.aninu.2017.06.007
Yang F, Hou C, Zeng X, Qiao S (2015) The use of lactic acid bacteria as a probiotic in swine diets. Pathogens 4:34–45. https://doi.org/10.3390/pathogens4010034
Bogere P, Choi YJ, Heo J (2019) Probiotics as alternatives to antibiotics in treating post-weaning diarrhoea in pigs: review paper. South African Journal of Animal Science 49:403–416. https://doi.org/10.4314/sajas.v49i3.1
FAO/WHO (2002) Report of a joint FAO/WHO working group on drafting guidelines for the evaluation of probiotics in food. Guidelines for the Evaluation of Probiotics in Food https://wwwwhoint/foodsafety/fs_management/en/probiotic_guidelinespdf Accessed 30 Apr 2020
Baccouri O, Boukerb AM, Farhat LB, Zébré A, Zimmermann K, Domann E, Cambronel M, Barreau M, Maillot O, Rincé I, Muller C, Marzouki MN, Feuilloley M, Abidi F, Connil N (2019) Probiotic potential and safety evaluation of Enterococcus faecalis OB14 and OB15, isolated from traditional tunisian testouri cheese and rigouta, using physiological and genomic analysis. Front Microbiol 10:881. https://doi.org/10.3389/fmicb.2019.00881
Guo X-H, Kim J-M, Nam H-M, Park SY, Kim JM (2010) Screening lactic acid bacteria from swine origins for multistrain probiotics based on in vitro functional properties. Anaerobe 16:321–326. https://doi.org/10.1016/j.anaerobe.2010.03.006
Porto MCW, Kuniyoshi TM, Azevedo POS, Vitolo M, Oliveira RPS (2017) Pediococcus spp.: an important genus of lactic acid bacteria and pediocin producers. Biotechnol Adv 35:361–374. https://doi.org/10.1016/j.biotechadv.2017.03.004
Sonnenborn U (2016) Escherichia coli strain Nissle 1917-from bench to bedside and back: history of a special Escherichia coli strain with probiotic properties. FEMS Microbiol Lett 363:https://doi.org/10.1093/femsle/fnw212
Barnes AMT, Dale JL, Chen Y, Manias DA, Greenwood Quaintance KE, Karau MK, Kashyap PC, Patel R, Wells CL, Dunny GM (2016) Enterococcus faecalis readily colonizes the entire gastrointestinal tract and forms biofilms in a germ-free mouse model. Virulence 8:282–296. https://doi.org/10.1080/21505594.2016.1208890
De Paepe M, Gaboriau-Routhiau V, Rainteau D et al (2011) Trade-off between bile resistance and nutritional competence drives Escherichia coli diversification in the mouse gut. PLoS Genet 7:e1002107. https://doi.org/10.1371/journal.pgen.1002107
Foster JW (2004) Escherichia coli acid resistance: tales of an amateur acidophile. Nat Rev Microbiol 2:898–907. https://doi.org/10.1038/nrmicro1021
Conway T, Cohen PS (2015) Commensal and pathogenic Escherichia coli metabolism in the gut. Microbiol Spectr 3. https://doi.org/10.1128/microbiolspec.MBP-0006-2014
Macfarlane S, Woodmansey EJ, Macfarlane GT (2005) Colonization of mucin by human intestinal bacteria and establishment of biofilm communities in a two-stage continuous culture system. Appl Environ Microbiol 71:7483–7492. https://doi.org/10.1128/AEM.71.11.7483-7492.2005
Vimont A, Fernandez B, Hammami R, Ababsa A, Daba H, Fliss I (2017) Bacteriocin-producing Enterococcus faecium LCW 44: a high potential probiotic candidate from raw camel milk. Front Microbiol 8:865. https://doi.org/10.3389/fmicb.2017.00865
Hanchi H, Hammami R, Kourda R, Hamida JB, Fliss I (2014) Bacteriocinogenic properties and in vitro probiotic potential of enterococci from Tunisian dairy products. Arch Microbiol 196:331–344. https://doi.org/10.1007/s00203-014-0978-y
Ben Braïek O, Smaoui S (2019) Enterococci: between emerging pathogens and potential probiotics. Biomed Res Int 2019:5938210–5938213. https://doi.org/10.1155/2019/5938210
Gillor O, Kirkup BC, Riley MA (2004) Colicins and microcins: the next generation antimicrobials. Adv Appl Microbiol 54:129–146. https://doi.org/10.1016/S0065-2164(04)54005-4
Gratia A, Fredericq P (1946) Diversité des souches antibiotiques de Bacterium coli et étendue variable de leur champ d’action. C R Soc Biol (Paris) 140:1032–1033
Qiu X-Q, Zhang J, Wang H, Wu GY (2005) A novel engineered peptide, a narrow-spectrum antibiotic, is effective against vancomycin-resistant Enterococcus faecalis. Antimicrob Agents Chemother 49:1184–1189. https://doi.org/10.1128/AAC.49.3.1184-1189.2005
Setia A, Bhandari SK, House JD et al (2009) Development and in vitro evaluation of an Escherichia coli probiotic able to inhibit the growth of pathogenic Escherichia coli K88. J Anim Sci 87:2005–2012. https://doi.org/10.2527/jas.2008-1400
Walker D, Behrens HM, Six A et al (2017) The therapeutic potential of bacteriocins as protein antibiotics. Emerg Top Life Sci 1:65–74. https://doi.org/10.1042/ETLS20160016
Cascales E, Buchanan SK, Duché D et al (2007) Colicin biology. Microbiol Mol Biol Rev 71:158–229. https://doi.org/10.1128/MMBR.00036-06
Ben Said L, Gaudreau H, Dallaire L, Tessier M, Fliss I (2019) Bioprotective culture: a new generation of food additives for the preservation of food quality and safety. Ind Biotechnol 15:138–147. https://doi.org/10.1089/ind.2019.29175.lbs
Henderson JT, Chopko AL, van Wassenaar PD (1992) Purification and primary structure of pediocin PA-1 produced by Pediococcus acidilactici PAC-1.0. Arch Biochem Biophys 295:5–12. https://doi.org/10.1016/0003-9861(92)90480-k
Papagianni M, Anastasiadou S (2009) Pediocins: the bacteriocins of pediococci. Sources, production, properties and applications. Microb Cell Factories 8:3. https://doi.org/10.1186/1475-2859-8-3
Gálvez A, Abriouel H, López RL, Ben Omar N (2007) Bacteriocin-based strategies for food biopreservation. Int J Food Microbiol 120:51–70. https://doi.org/10.1016/j.ijfoodmicro.2007.06.001
Franz CMAP, van Belkum MJ, Holzapfel WH, Abriouel H, Gálvez A (2007) Diversity of enterococcal bacteriocins and their grouping in a new classification scheme. FEMS Microbiol Rev 31:293–310. https://doi.org/10.1111/j.1574-6976.2007.00064.x
Drider D, Fimland G, Héchard Y et al (2006) The continuing story of class IIa bacteriocins. Microbiol Mol Biol Rev 70:564–582. https://doi.org/10.1128/MMBR.00016-05
Rodríguez JM, Martínez MI, Kok J (2002) Pediocin PA-1, a wide-spectrum bacteriocin from lactic acid bacteria. Crit Rev Food Sci Nutr 42:91–121. https://doi.org/10.1080/10408690290825475
Belguesmia Y, Alard J, Mendil R, Ravallec R, Grangette C, Drider D, Cudennec B (2019) In vitro probiotic properties of selected lactobacilli and multi-strain consortium on immune function, gut barrier strengthening and gut hormone secretion. J Funct Foods 57:382–391. https://doi.org/10.1016/j.jff.2019.04.028
McFarland LV (2020) Efficacy of single-strain probiotics versus multi-strain mixtures: systematic review of strain and disease specificity. Digest Dis Sci. https://doi.org/10.1007/s10620-020-06244-z
Eveno M, Salouhi A, Belguesmia Y, Bazinet L, Gancel F, Fliss I, Drider D (2020) Biodiversity and phylogenetic relationships of novel bacteriocinogenic strains isolated from animal’s droppings at the zoological garden of Lille, France. Probiotics Antimicrob Proteins https://doi.org/10.1007/s12602-020-09657-4
de Man JC, Rogosa M, Sharpe ME (1960) A medium for the cultivation of lactobacilli. J Appl Bacteriol 23:130–135. https://doi.org/10.1111/j.1365-2672.1960.tb00188.x
CLSI (2020) M100Ed30 | performance standards for antimicrobial susceptibility testing, 30th Edition. In: Clinical & Laboratory Standards Institute. https://clsi.org/standards/products/microbiology/documents/m100/. Accessed 30 Apr 2020
Stepanović S, Cirković I, Ranin L, Svabić-Vlahović M (2004) Biofilm formation by Salmonella spp. and Listeria monocytogenes on plastic surface. Lett Appl Microbiol 38:428–432. https://doi.org/10.1111/j.1472-765X.2004.01513.x
Demers-Mathieu V, St-Gelais D, Audy J, et al (2013) Biocompatibility between new probiotic strains isolated and commercial mesophilic or thermophilic strains. Colloque STELA/Symposium FIL-IDF Canada, at Québec, Canada 13-16 May 2013. https://www.researchgate.net/publication/269333822_BIOCOMPATIBILITY_BETWEEN_NEW_PROBIOTIC_STRAINS_ISOLATED_AND_COMMERCIAL_MESOPHILIC_OR_THERMOPHILIC_STRAINS. Accessed 30 April 2020
Schillinger U, Lücke FK (1989) Antibacterial activity of Lactobacillus sake isolated from meat. Appl Environ Microbiol 55:1901–1906
Kheadr E, Zihler A, Dabour N, Lacroix C, le Blay G, Fliss I (2010) Study of the physicochemical and biological stability of pediocin PA-1 in the upper gastrointestinal tract conditions using a dynamic in vitro model. J Appl Microbiol 109:54–64. https://doi.org/10.1111/j.1365-2672.2009.04644.x
Haakensen M, Vickers DM, Ziola B (2009) Susceptibility of Pediococcus isolates to antimicrobial compounds in relation to hop-resistance and beer-spoilage. BMC Microbiol 9:190. https://doi.org/10.1186/1471-2180-9-190
Klare I, Konstabel C, Werner G, Huys G, Vankerckhoven V, Kahlmeter G, Hildebrandt B, Müller-Bertling S, Witte W, Goossens H (2007) Antimicrobial susceptibilities of Lactobacillus, Pediococcus and Lactococcus human isolates and cultures intended for probiotic or nutritional use. J Antimicrob Chemother 59:900–912. https://doi.org/10.1093/jac/dkm035
Oh S-W, Chen P-C, Kang D-H (2007) Biofilm formation by Enterobacter sakazakii grown in artificial broth and infant milk formula on plastic surface. Journal of Rapid Methods & Automation in Microbiology 15:311–319. https://doi.org/10.1111/j.1745-4581.2007.00103.x
López-García J, Lehocký M, Humpolíček P, Sáha P (2014) HaCaT keratinocytes response on antimicrobial atelocollagen substrates: extent of cytotoxicity, cell viability and proliferation. J Funct Biomater 5:43–57. https://doi.org/10.3390/jfb5020043
Fijan S (2016) Antimicrobial effect of probiotics against common pathogens. In Rao V and Rao LG (ed) Human nutrition and health, IntechOpen. London, UK. https://www.intechopen.com/books/probiotics-and-prebiotics-in-human-nutrition-and-health/antimicrobial-effect-of-probiotics-against-common-pathogens. Accessed 30 April 2020
Vieco-Saiz N, Belguesmia Y, Raspoet R, Auclair E, Gancel F, Kempf I, Drider D (2019) Benefits and inputs from lactic acid bacteria and their bacteriocins as alternatives to antibiotic growth promoters during food-animal production. Front Microbiol 10:57. https://doi.org/10.3389/fmicb.2019.00057
Hancock LE, Perego M (2004) The Enterococcus faecalis fsr two-component system controls biofilm development through production of gelatinase. J Bact 186(17):5629–5639. https://doi.org/10.1128/JB.186.17.5629-5639.2004
Shruthi N et al (2012) Phenotypic study of virulence factors in Escherichia coli isolated from antenatal cases, catheterized patients, and faecal flora. J Clin Diagn Res 6(10):1699–1703. https://doi.org/10.7860/JCDR/2012/4669.2634
Borges S, Teixeira P (2014) Pediococcus pentosaceus SB83 as a potential probiotic incorporated in a liquid system for vaginal delivery. Benef Microbes 5:421–426. https://doi.org/10.3920/BM2013.0084
Suvorov A (2020) What is wrong with enterococcal probiotics? Probiotics Antimicrob Proteins 12:1–4. https://doi.org/10.1007/s12602-020-09633-y
Franz CMAP, Huch M, Abriouel H, Holzapfel W, Gálvez A (2011) Enterococci as probiotics and their implications in food safety. Int J Food Microbiol 151:125–140. https://doi.org/10.1016/j.ijfoodmicro.2011.08.014
Shanahan F (2001) Probiotics in inflamatory bowel disease. Gut 48:609. https://doi.org/10.1136/gut.48.5.609
Amer M, Nadeem M, Nazir SUR, Fakhar M, Abid F, Ain QU, Asif E (2018) Probiotics and their use in inflammatory bowel disease. Altern Ther Health Med 24:16–23
Marteau P, Minekus M, Havenaar R, Huis in’t Veld JH (1997) Survival of lactic acid bacteria in a dynamic model of the stomach and small intestine: validation and the effects of bile. J Dairy Sci 80:1031–1037. https://doi.org/10.3168/jds.S0022-0302(97)76027-2
Minekus M, Marteau P, Havenaar R, Huis in’t Veld JHH (1995) Multicompartmental dynamic computer-controlled model simulating the stomach and small intestine. Alternatives to laboratory animals : ATLA 23(2):197–209
Khalf M, Dabour N, Kheadr E, Fliss I (2010) Viability of probiotic bacteria in maple sap products under storage and gastrointestinal conditions. Bioresour Technol 101:7966–7972. https://doi.org/10.1016/j.biortech.2010.05.053
Venema K, Verhoeven J, Verbruggen S, Espinosa L, Courau S (2019) Probiotic survival during a multi-layered tablet development as tested in a dynamic, computer-controlled in vitro model of the stomach and small intestine (TIM-1). Lett Appl Microbiol 69:325–332. https://doi.org/10.1111/lam.13211
Naimi S, Zirah S, Hammami R, Fernandez B, Rebuffat S, Fliss I (2018) Fate and biological activity of the antimicrobial lasso peptide microcin J25 under gastrointestinal tract conditions. Front Microbiol 9:1764. https://doi.org/10.3389/fmicb.2018.01764
Blanquet S, Zeijdner E, Beyssac E, Meunier JP, Denis S, Havenaar R, Alric M (2004) A dynamic artificial gastrointestinal system for studying the behavior of orally administered drug dosage forms under various physiological conditions. Pharm Res 21:585–591. https://doi.org/10.1023/b:pham.0000022404.70478.4b
Brouwers J, Anneveld B, Goudappel G-J, Duchateau G, Annaert P, Augustijns P, Zeijdner E (2011) Food-dependent disintegration of immediate release fosamprenavir tablets: in vitro evaluation using magnetic resonance imaging and a dynamic gastrointestinal system. Eur J Pharm Biopharm 77:313–319. https://doi.org/10.1016/j.ejpb.2010.10.009
Dickinson PA, Abu Rmaileh R, Ashworth L, Barker RA, Burke WM, Patterson CM, Stainforth N, Yasin M (2012) An investigation into the utility of a multi-compartmental, dynamic, system of the upper gastrointestinal tract to support formulation development and establish bioequivalence of poorly soluble drugs. AAPS J 14:196–205. https://doi.org/10.1208/s12248-012-9333-x
Chen L, Hébrard G, Beyssac E et al (2010) In vitro study of the release properties of soy-zein protein microspheres with a dynamic artificial digestive system. J Agric Food Chem 58:9861–9867. https://doi.org/10.1021/jf101918w
Nimalaratne C, Savard P, Gauthier SF, Schieber A, Wu J (2015) Bioaccessibility and digestive stability of carotenoids in cooked eggs studied using a dynamic in vitro gastrointestinal model. J Agric Food Chem 63:2956–2962. https://doi.org/10.1021/jf505615w
Torres-Escribano S, Denis S, Blanquet-Diot S, Calatayud M, Barrios L, Vélez D, Alric M, Montoro R (2011) Comparison of a static and a dynamic in vitro model to estimate the bioaccessibility of As, Cd, Pb and Hg from food reference materials Fucus sp. (IAEA-140/TM) and Lobster hepatopancreas (TORT-2). Sci Total Environ 409:604–611. https://doi.org/10.1016/j.scitotenv.2010.10.021
Gänzle MG, Hertel C, van der Vossen JM, Hammes WP (1999) Effect of bacteriocin-producing lactobacilli on the survival of Escherichia coli and Listeria in a dynamic model of the stomach and the small intestine. Int J Food Microbiol 48:21–35. https://doi.org/10.1016/s0168-1605(99)00025-2
Fernandez B, Hammami R, Savard P, Jean J, Fliss I (2014) Pediococcus acidilactici UL5 and Lactococcus lactis ATCC 11454 are able to survive and express their bacteriocin genes under simulated gastrointestinal conditions. J Appl Microbiol 116:677–688. https://doi.org/10.1111/jam.12391
Nueno-Palop C, Narbad A (2011) Probiotic assessment of Enterococcus faecalis CP58 isolated from human gut. Int J Food Microbiol 145:390–394. https://doi.org/10.1016/j.ijfoodmicro.2010.12.029
Cebrián R, Baños A, Valdivia E, Pérez-Pulido R, Martínez-Bueno M, Maqueda M (2012) Characterization of functional, safety, and probiotic properties of Enterococcus faecalis UGRA10, a new AS-48-producer strain. Food Microbiol 30:59–67. https://doi.org/10.1016/j.fm.2011.12.002
Funding
Mégane Eveno received a Ph.D. scholar fellowship from l’Université de Lille (France) and Université Laval (Québec, Canada) through the Natural Sciences and Engineering Research Council of Canada (NSERC) METABIOLAC Industrial Research Chair awarded to Professor Ismail Fliss and the NSERC Industrial Research Chair on Electro-Membrane processes for the ecoefficiency improvement of bio-food production lines (Grant IRCPJ 492889-15 to Laurent Bazinet). Research at Université de Lille was supported by a CPER/FEDER Alibiotech grant (2016-2021) awarded by the Région des Hauts de France.
Author information
Authors and Affiliations
Corresponding author
Ethics declarations
Conflict of Interest
The authors declare that they have no conflict of interest.
Additional information
Publisher’s Note
Springer Nature remains neutral with regard to jurisdictional claims in published maps and institutional affiliations.
Rights and permissions
About this article
Cite this article
Eveno, M., Savard, P., Belguesmia, Y. et al. Compatibility, Cytotoxicity, and Gastrointestinal Tenacity of Bacteriocin-Producing Bacteria Selected for a Consortium Probiotic Formulation to Be Used in Livestock Feed. Probiotics & Antimicro. Prot. 13, 208–217 (2021). https://doi.org/10.1007/s12602-020-09687-y
Published:
Issue Date:
DOI: https://doi.org/10.1007/s12602-020-09687-y